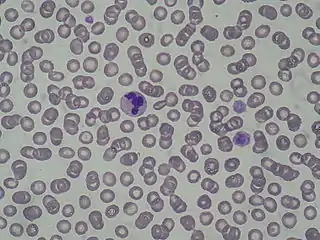

Anomalía de May-Hegglin
La anomalía de de May-Hegglin [nota 1] es una enfermedad de la sangre poco frecuente que se incluye dentro del grupo de trastornos denominados trombopenias hereditarias. Se caracteriza por disminución del número de plaquetas en sangre (plaquetopenia), las plaquetas son sin embargo de tamaño mayor al normal (plaquetas gigantes) y al microscopio se pueden observar unos cuerpos de inclusión de color azulado en los leucocitos que se denominan cuerpos de Döhle. El trastorno es hereditario y está presente desde el nacimiento, puede no ocasionar síntomas, pero existe propensión a las hemorragias que tienden a manifestarse en el transcurso de una intervención quirúrgica. Los estudios genéticos han demostrado que la anomalía de May-Hegglin es una de las 5 enfermedades hereditarias que cursan con plaquetas gigantes, todas ellas producidas por mutaciones que afectan al mismo gen (gen MYH9). Las otros trastornos del mismo grupo son el Síndrome de Sebastian, el Síndrome de Fechtner, el Síndrome de Epstein, y el Síndrome de Alport-like.[1][2]
| Anomalía de May-Hegglin | ||
|---|---|---|
| ||
| Especialidad | hematología | |
Historia
En el año 1909 el médico alemán Richard May (1836-1936) describió la existencia de cuerpos de inclusión en los leucocitos de un paciente asintomático (cuerpos de Döhle), en 1945 el suizo Robert Hegglin observó la presencia de trombopenia, plaquetas gigantes y cuerpos de inclusión de varios pacientes pertenecientes a la misma familia. La denominación de la enfermedad toma el nombre de estós dos médicos que contribuyeron al descubrimiento y estudio de la afección.[3][4][5]
Herencia

Se hereda según un patrón autosómico dominante.
Notas
- Esta enfermedad ha sido excluida de Orphanet como enfermedad rara y trasladada a Tromocitopenia relacionada con MYH9.
Referencias
- National Organization for Rara Disorders: May Hegglin Anomaly. Consultado el 9 de junio de 2016
- OMIM 155100
- synd/113 en Who Named It?
- R. May. Leukocyteneinschlüsse. Kasuistische Mitteilung. Deutsches Archiv für klinische Medizin, Leipzig, 1909, 96: 1-6.
- R. Hegglin. Über eine neue Form einer konstitutionellen Leukozytenanomalie, kombiniert mit Throbopathie. Schweizerische medizinische Wochenschrift, Basel, 1945, 75: 91-92.